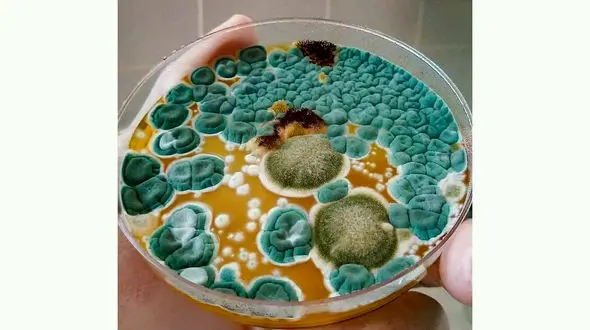
ماجرای عجیب ظرف یک پژوهشگر + عکس

عجیب
5629نتیجه جستجو :
-
هشدارهای سرطانی روی ناخن
سلامت رکنا : برخی علائم روی ناخن نشانه سرطان پوست است.
-
برادرکشی راننده تاکسی در تهران! / دستور داشتم برادر فاسد را بکشم!
حوادث رکنا: راننده تاکسی که در درگیری با برادر بیمارش وی را کشته بود در حالی پای میز محاکمه ایستاد که رضایت اولیایدم را جلب کرد و مدعی شد برای نجات جان پسرش ناچار به چاقوکشی شده است.
-
فیلم لحظه مرگ مردی که با عزرائیل شوخی کرد! / در کرمانشاه رخ داد
حوادث رکنا: اظهارات عجیب غریق نجاتی که یک جسد را از آب بیرون کشید در این گزارش بخوانید.فرد فوت شده در آخرین لحظات عمرش می خواست شبیه غریق نجات معروفش شنا کند اما غرق شد و همان غریق نجات او را نجات دا…
-
خشم عجیب رونالدو از نوشابه های روی میز + فیلم
رکنا : واکنش کریستیانو رونالدو به نوشابه های موجود در نشست خبری حاشیه ساز شد.
-
ماجرای عجیب ظرف یک پژوهشگر + عکس
رکنا : نتیجه آزمایش یک پژوهشگر به طراحی جالبی روی ظرف ختم شد.
-
پشت پرده کشف یک موجود ترسناک در جاده رفسنجان + فیلم
حوادث رکنا : ماجرای کشف موجود عجیب در جاده نوق رفسنجان چیست؟
-
افزایش عجیب قیمت برنج در بازار + قیمت
اقتصادی رکنا: هم اکنون قیمت هر کیلو برنج هندی ۲۲ تا ۲۳ هزار تومان، برنج پاکستانی ۲۴ تا ۲۶ هزار تومان و برنج ایرانی ۲۸ تا ۴۲ هزار تومان است که در مقایسه با مدت مشابه سال قبل افزایش چشمگیری داشته است.
-
واکسن کرونا بزن ، خودرو جایزه بگیر!
رکنا : شهردار مسکو اعلام کرد که برای تشویق مردم به زدن واکسن کرونا ماشین جایزه می دهد.
-
درمان گردن درد به روش چینی + فیلم
رکنا : گردن درد از شایع ترین عوارض جسمی و عضلانی بین افراد به ویژه کارمندان است.
-
دکوراسیون این رستوران با دلارها شکل گرفت + عکس
رکنا : یک رستوران محلی به دلیل ایده دکوراسیون منحصر به فرد و عجیبش شهرت زیادی پیدا کرده است.
-
کوه های رنگی کشورمان را دیده اید؟ + فیلم
رکنا : منابع طبیعی کشورمان از جمله کوه ها زیبایی های خاص خود را دارد.
-
تولد قد بلندترین نوزاد سنگین وزن دنیا + عکس
حوادث رکنا: نوزادی سنگین وزن در بیمارستان انگلیس به دنیا آمد.
رک پلاس
- نیما شعبان نژاد چرا ازدواج نکرده است؟ / پاسخ متفاوت این بازیگر به سوال مهران مدیری
- فیلم/فلامک جنیدی: عروسی مان را خیلی ساده در ایران گرفتیم نه لندن؛ گلایه بامزه بهنوش بختیاری از دعوت نشدن به مراسم دوست 20 ساله اش
- عکس پربازدید رضا رشیدپور و دخترش؛ روایت جالب گذر زمان در یک قاب پدر و دختری
- خلوت دونفره و عاشقانه المیرا دهقانی و همسرش در کنار ساحل مورد توجه قرار گرفت + عکس
- فیلم/دانیال خیری خواه از مصدومیت شدید در سریال «بی عاطفه» گفت / شکستگی دست و پا به خاطر یک سکانس اکشن
- سکانس متفاوت فاطمه مسعودیفر و امیر نوروزی زن و شوهر سریال در «گل سنگ» خبرساز شد؛ تغییر مرزهای روایت در نمایش خانگی؟
- فیلم / خیانت شوهر با دوست صمیمی همسر / ویدیویی که جنجال به پا کرد
- بازآفرینی صدای محسن لرستانی در آهنگ «مخوام به او خدا بگم چه کردی با مه» / هوش مصنوعی سبک اورا هم تقلید کرد
- فیلم لحظه عقد عروس ایرانی که قبل از بله گفتن یک کار غیرمنتظره انجام داد!
- فیلم/ روایت عاشقانه شبنم قلی خانی از ازدواجش؛ همه چیز با یک ماکت دانشجویی و نقشه خواهرم شروع شد
- فیلم منتشر شده از اعتراف مجید سالک / قاتل ۴۹ زن که در زندان قصر به زندگیاش پایان داد
- نامه سارق پشیمان در اراک / به نام خدا، سلام داداش خوبی + عکس نامه با دستخط
- فیلم ازدواج یک پسر با دو دختر از اقوام / رضایت هر دو عروس در ویدیو دیده میشود
- روایت بهاره رهنما از یک رابطه در پشت صحنه یک فیلم/بهاره رهنما: وقتی فهمیدم کارگردان متاهل است، به آن بازیگر تذکر دادم
- عکس/ تغییر چهره شیوا مکی نیان، بازیگر «پایتخت» 2 سال بعد از سریال/ شری را این شکلی ندیده بودید
- «دیگه برگشتم خیاله» با صدای شادمهر عقیلی؛ بازآفرینی یک آهنگ عاشقانه با هوش مصنوعی
- فیلم/ واکنش تند ژیلا صادقی به منتقدانش؛ شهروند آمریکا هستم اما ایران را به دنیا معرفی می کنم
- یادی کنیم از عکس عاشقانه سپهر حیدری برای همسرسابقش که پربازدید شد/ از کیک تولد لاکچری تا کادوهای گران قیمت برای آرام جوینده
- فیلم/ جلوه اصالت ایرانی در استایل بازیگران زن؛ الهام حمیدی، مونا کرمی و هلیا امامی در یک قاب متفاوت
- فیلم / نهر داریون شوشتر روایت نبوغ ایرانیان در مدیریت آب / برای گردش سری به این تمدن ایرانی بزنید